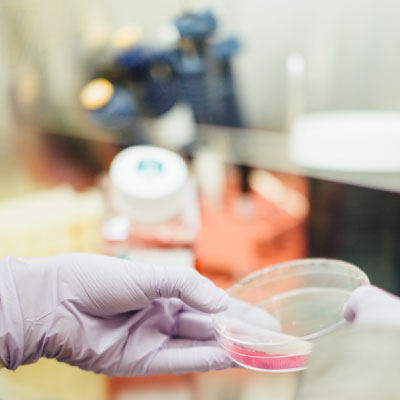

Solutions
linguistiques
sur mesure
Ecosse Connection, pour la réussite de votre communication à travers langues et cultures
EN CE MOMENT !
La traduction à l’honneur
Vous avez besoin de faire traduire des documents mais vous ne savez pas vers qui vous tourner? Notre équipe de professionnels est là pour répondre à tous vos besoins en vous assurant la plus haute qualité de service.
Découvrez nos services
[ Vous êtes à la recherche d’un service de traduction/interprétation,
d’une formation spécialisée en langue ou T&I, de conseils experts
en matière de communication interculturelle ?
Ne cherchez plus, nous avons une solution adaptée à vos besoins.
TRADUCTION / INTERPRÉTATION
FORMATIONS
CONSEIL INTERCULTUREL
TRADUCTION / INTERPRÉTATION
Formations
CONSEIL INTERCULTUREL
TRADUCTION / INTERPRÉTATION
Formations
CONSEIL INTERCULTUREL
Notre approche
[ Chez Ecosse Connection, notre savoir-faire est à votre service,
quels que soient vos besoins, avec un accompagnement personnalisé
de la demande à la livraison.
-
-1-
[ Définition du projet ]Le gestionnaire assigné à votre projet répond à votre requête initiale dans un délai d’un jour ouvré et définit vos besoins avec vous
-
-2-
[ Proposition & devis ]Une fois les meilleurs professionnels retenus pour l’exécution du projet, un devis détaillé vous est soumis dans les plus brefs délais
-
-3-
[ Confirmation ]Le cahier des charges définitif est approuvé par vous
-
-4-
[ Exécution ]Le service demandé est réalisé conformément au cahier des charges
-
-5-
[ Contrôle qualité ]Un contrôle qualité systématique est effectué avant, pendant et/ou après l’exécution du projet en fonction du service requis
Nos engagements
[ Les valeurs qui nous tiennent à cœur en fondement de nos activités ]
Nos engagements
[ Les valeurs qui nous tiennent à cœur en fondement de nos activités !

Solutions sur mesure
Des réponses adaptées à vos demandes

Équipe
Une équipe de spécialistes à votre écoute

Réponses
Un délai de traitement rapide

Contact
La garantie d’un interlocuteur unique

Qualité
Un contrôle qualité systématique

Responsabilité
Un véritable engagement sociétal
L’ univers Ecosse Connection
[ Des spécialistes, un service personnalisé de qualité pour répondre à vos besoins !

Isabelle Perez
Directrice de Ecosse Connection Ltd
Installée à Edimbourg depuis près de 35 ans, je suis interprète et formatrice d’interprètes. Au terme d’une longue carrière universitaire dans le domaine de la traduction/interprétation, l’université de Heriot-Watt (Edimbourg) m’a conféré le titre de Professeur Émérite en 2018.
Mes expertises
Dans ce contexte, j’ai dirigé ou participé à bon nombre de programmes nationaux et internationaux sur l’interprétation en milieu social, tels l’étude des interrogatoires de police par l’intermédiaire d’interprètes ou encore l’accès aux services de santé mentale pour des populations de patients linguistiquement et culturellement diverses. Cette recherche a débouché sur des publications et sur l’élaboration de programmes de formation destinés aux interprètes autant qu’aux professions médicales/juridiques servies.
Cette expertise, doublée d’une expérience acquise à tous les niveaux du management et de la gouvernance dans l’enseignement supérieur, m’ont équipée pour répondre à vos besoins en matière de gestion de projets ou d’équipes à l’international.

Mathilde Guillemet
Directrice de Ecosse Connection Ltd
Interprète, traductrice et enseignante, j’ai étudié et travaillé dans différentes villes d’Europe pendant près de deux décennies, et j’ai décidé de revenir m’installer en France. Grâce à ce parcours, j’ai pu développer, entre autres, une expertise particulière dans le domaine de la communication interculturelle et de l’enseignement spécialisé des langues.
Mes expertises
Après une maîtrise en traduction et affaires internationales à l’ISIT, Paris, un master en Communication interculturelle et relations internationales à l’Université de Newcastle, et un autre en interprétation à l’ISTI, Bruxelles, je me suis lancée en tant que traductrice/interprète indépendante, tout en enseignant à l’Institut français d’Ecosse et à l’Université de Heriot-Watt à Edimbourg où j’ai développé des programmes de formation continue pour les traducteurs et interprètes, ainsi que pour les professionnels du monde des affaires et de l’administration.
Grâce à une approche multidisciplinaire et des expériences de terrain, j’ai à ma disposition les outils nécessaires pour répondre à vos besoins rapidement et avec un service de haute qualité.

À propos d’ Ecosse Connection
Nous pensons que le monde est en pleine mutation et que demain l’interconnexion, la solidarité et la coopération devront être les maîtres mots. Pour les concrétiser, il faudra que les individus et les organisations puissent communiquer entre eux, au-delà de la barrière de la langue bien sûr, mais également grâce à une véritable compréhension de l’autre et célébration des spécificités culturelles de chacun. Faciliter cette communication est l’objectif premier d’Ecosse Connection.
Contactez-nous !
[ Faites appel à nous pour un devis sans engagement ]
NOTRE AGENCE FRANCE
ECOSSE CONNECTION LTD
34, Quai de la Loire
49 350 Les Rosiers sur Loire
contact@ecosseconnection.com
+33(0)6 51 34 84 60